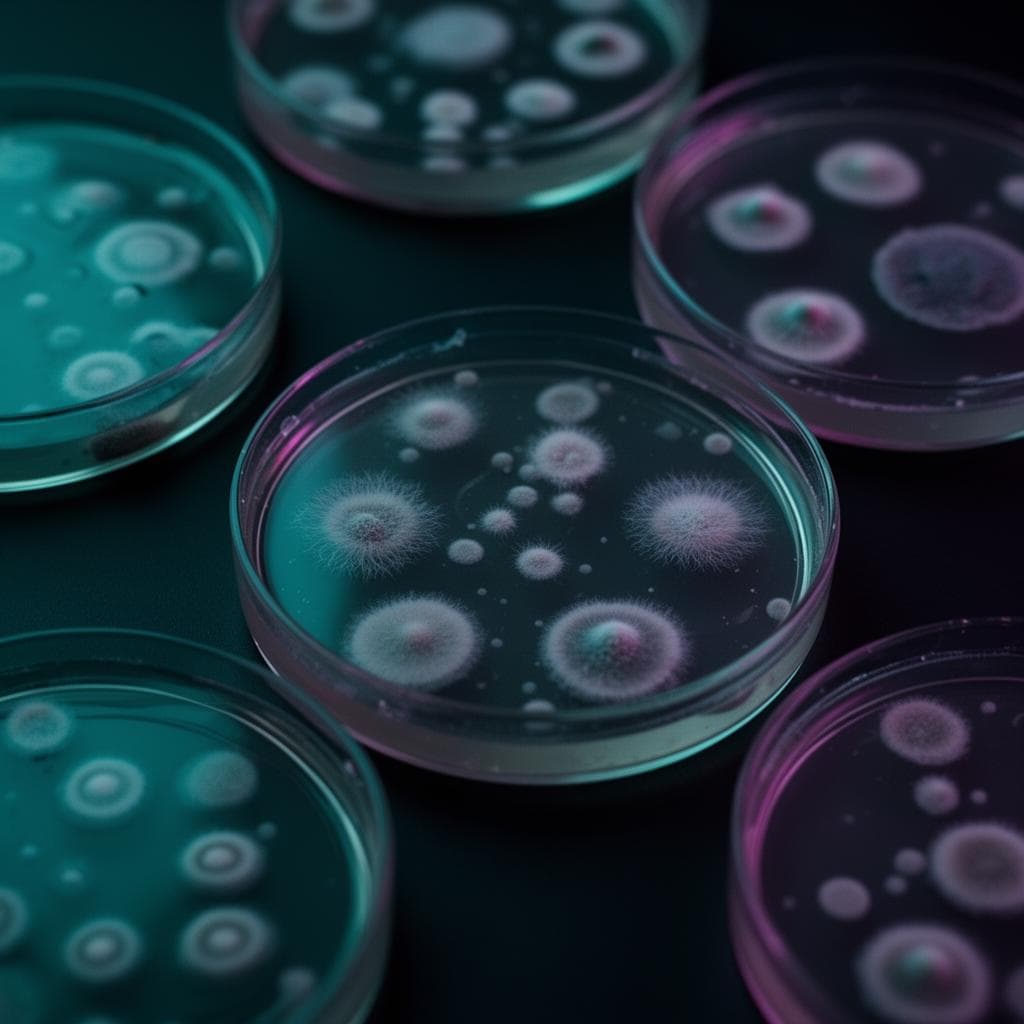
Psilocybin Use illustration 3

Clinical vs. Wellness: Two Paths for Psilocybin
Quick Summary
Psilocybin has two main uses. The clinical model uses high, infrequent doses with therapists to treat conditions like depression. The wellness model uses small, regular microdoses at home to improve mood and focus. These two approaches serve different goals and should not be confused.




The modern landscape of psilocybin is defined by a significant divergence. On one path, clinical researchers explore high, infrequent doses in medically supervised settings to treat severe mental health conditions. On the other, millions of individuals are self-directing low-dose wellness routines to enhance daily life. A 2026 RAND study highlighted this trend, revealing that for the 11 million U.S. adults who used psilocybin in the past year, nearly half of all use days involved microdosing. These are not competing modalities but distinct applications of the same compound for entirely different purposes. Understanding the goals, methods, and safety considerations of each is essential for anyone interested in psilocybin today.
What is the Clinical Model?
The clinical model, exemplified by institutions like the Johns Hopkins Center for Psychedelic and Consciousness Research, is best described as psilocybin-assisted therapy. This approach is characterized by the administration of a single, high dose (typically 20-30mg of pure psilocybin) within a controlled therapeutic environment. The goal is not daily enhancement but a profound, often mystical, experience that can act as a catalyst for psychological breakthroughs.
Key features of the clinical model include:
- High Doses: The aim is to induce a powerful psychedelic experience, which researchers believe is integral to the therapeutic outcome.
- Professional Supervision: Patients are guided by two trained facilitators or therapists throughout the entire session, which can last 6-8 hours.
- Structured Setting: The environment is carefully curated with a comfortable couch, eye shades, and a specific music playlist to help guide the internal experience.
- Therapeutic Integration: The psilocybin session is bracketed by multiple preparatory and integration therapy sessions. The experience itself is not the treatment; the treatment is the therapy that psilocybin facilitates.
- Targeted Conditions: This model is being studied for specific, often treatment-resistant conditions, such as major depressive disorder, post-traumatic stress disorder (PTSD), and addiction.
The primary objective is to address severe psychological distress. The powerful experience is thought to increase brain plasticity, helping individuals break out of rigid, negative patterns of thought and behaviour that are characteristic of these conditions.
What is the Wellness Model?
In contrast, the wellness model is defined by its use of sub-perceptual doses, a practice commonly known as microdosing. This approach has grown organically from community use, not clinical labs. As the RAND study shows, it is an extremely common practice among people who use psilocybin. Users take a small fraction of a recreational dose—typically 50mg to 150mg of dried mushroom material—according to a schedule.
Key features of the wellness model include:
- Sub-Perceptual Doses: The dose is small enough that it does not produce a noticeable psychedelic effect or alter consciousness, allowing users to go about their daily activities.
- Regular Schedule: Unlike the one or two sessions in a clinical course of treatment, microdosing involves a regular cadence, such as one day on, two days off. For a deeper dive into this, our post on common microdosing schedules explained offers a detailed overview.
- Self-Direction: Individuals manage their own dose, schedule, and intention. The goal is not to have a transformative experience but to achieve subtle improvements in mood, creativity, focus, and social connection over time.
- General Enhancement: The aim is not to treat a diagnosed illness but to optimize well-being. It is used more like a vitamin or supplement for the mind.
For those pursuing the wellness path, precision and convenience are key. Products like our Clarity Microdose Capsules are designed to provide a consistent, pre-measured dose, removing the guesswork involved in this model of use. This makes integration into a daily routine seamless, which is the primary goal for wellness users.
Why Do Both Models Coexist?
The clinical and wellness paths for psilocybin are not in conflict; they simply serve different human needs. The coexistence of these two models can be compared to other areas of health and medicine. For instance, an orthopedic surgeon performs a knee replacement to fix a debilitating injury—this is an acute, high-intervention a_pproach analogous to clinical psilocybin therapy. In contrast, a person might engage in daily stretching, foam rolling, and take joint supplements to maintain mobility and prevent future issues. This is a low-dose, frequent, and self-directed wellness practice, much like microdosing.
One model addresses a crisis, while the other supports ongoing stability. Much of the media alarm around microdosing stems from confusing the two. Applying the safety standards of high-dose clinical therapy to low-dose wellness use is a fundamental mismatch of context. The safety concerns of a powerful, consciousness-altering experience are entirely different from those of a sub-perceptual dose. Both require education and responsible use, but the protocols are rightly different because the intentions and effects are worlds apart. Many users find versatile products useful, which can be found across our shop.
How Do Efficacy and Safety Differ?
In the clinical model, efficacy is measured with standardized psychiatric rating scales. A study is successful if participants show a statistically significant reduction in symptoms of depression, for example. Safety is managed through intensive screening of participants and real-time monitoring by medical professionals. The primary risks addressed are psychological, such as managing potential anxiety, paranoia, or overwhelming emotional experiences during the session.
In the wellness model, efficacy is subjective and personal. Success might be a self-reported improvement in mood, a more productive workday, or a greater sense of connection with others. Safety is managed through personal responsibility. This includes starting with a very low dose, understanding one's own psychological state, avoiding use during times of emotional turmoil, and being aware of the source and potency of the product. The science of this is still emerging, but understanding concepts like in our article on Lemon Tekking Explained: The Science can inform a user's approach to dosing.
The Wonder Chocolate Bar is a product that highlights this difference. While a whole bar might be used for a macrodose experience, a single square can serve as a microdose or a low dose. The user's intention and dose selection determine which path they are walking, and the responsibility shifts accordingly.
As research continues to evolve, the distinctions between these two powerful applications for psilocybin will become clearer. Both paths, when navigated with respect and education, represent a significant shift in how we approach both mental illness and the pursuit of human wellness.
ShroomDash Editorial Team
Published 2026-04-05 · 5 min read read · Lab Science